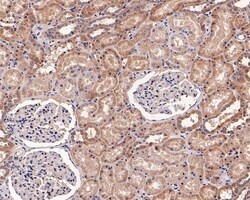
Invitrogen RALA Recombinant Rabbit Monoclonal Antibody (JE54-12) 100 &mu;L;

Learn More
Invitrogen™ RALA Recombinant Rabbit Monoclonal Antibody (JE54-12)


Rabbit Recombinant Monoclonal Antibody
Brand: Invitrogen™ MA550740
Description
Positive control: LOVO cell lysate, HCT116 cell lysate, HT-29 cell lysate, SW480 cell lysate, 293 cell lysate, human kidney tissue lysate, human colon tissue, human colon carcinoma tissue, human kidney tissue, HUVEC. Predicted band size: 24 kDa Subcellular Location: Cell membrane, Mitochondrion.
Multifunctional GTPase involved in a variety of cellular processes including gene expression, cell migration, cell proliferation, oncogenic transformation and membrane trafficking. Accomplishes its multiple functions by interacting with distinct downstream effectors. Acts as a GTP sensor for GTP-dependent exocytosis of dense core vesicles. Plays a role in the early stages of cytokinesis and is required to tether the exocyst to the cytokinetic furrow. The RALA-exocyst complex regulates integrin-dependent membrane raft exocytosis and growth signaling. Key regulator of LPAR1 signaling and competes with GRK2 for binding to LPAR1 thus affecting the signaling properties of the receptor. Required for anchorage-independent proliferation of transformed cells.
Specifications
| RALA | |
| Recombinant Monoclonal | |
| 1 mg/mL | |
| TBS with 0.05% BSA, 40% glycerol and 0.05% sodium azide; pH 7.4 | |
| P11233 | |
| Rala | |
| Recombinant protein within Human RALA aa 107-206/206. | |
| 100 μL | |
| Primary | |
| Human | |
| Antibody | |
| IgG |
| Flow Cytometry, Immunohistochemistry (Paraffin), Western Blot | |
| JE54-12 | |
| Unconjugated | |
| Rala | |
| 3010001O15Rik; AW322615; MGC48949; Ral; -ral simian leukemia viral oncogene homolog A (ras related); RALA; Ral-a; ral-A protein; RALA Ras like proto-oncogene A; Ras family small GTP binding protein RALA; ras related GTP binding protein A; Rasl1; RAS-like protein A; RAS-like, family 1; ras-related protein Ral-A; v-ral simian leukemia viral oncogene homolog A (ras related) | |
| Rabbit | |
| Protein A | |
| RUO | |
| 5898 | |
| Store at 4°C short term. For long term storage, store at -20°C, avoiding freeze/thaw cycles. | |
| Liquid |
Your input is important to us. Please complete this form to provide feedback related to the content on this product.